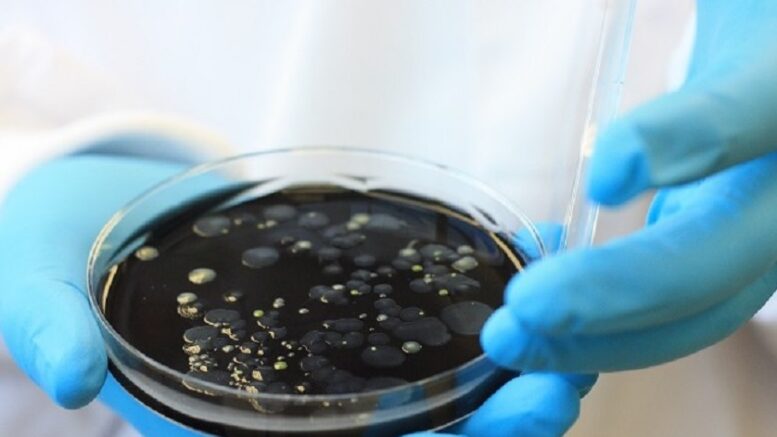

A seguito di alcuni rilevamenti di legionella nel territorio di Ortona, uno dei quali anche presso una torre dello stabilimento Ontex, l’azienda fornisce alcuni elementi a suo dire “utili a chiarire il quadro”.
“Non vi sono al momento elementi che possano collegare la presenza di legionella nelle torri con i casi verificatisi in varie località del Comune di Ortona, come riportato dalla stessa relazione dell’ISS.
La prevenzione è stata scrupolosa, tanto che non si sono ad oggi verificati casi di legionella all’interno della popolazione aziendale, né tra i dipendenti delle ditte di manutenzione che lavorano presso le torri di raffreddamento, in teoria più esposti.
Le torri sono in ogni caso attualmente spente come da programma, in quanto vengono utilizzate solo nel periodo estivo e normalmente arrestate entro la fine di settembre di ogni anno.
Le stesse acque che alimentano le torri sono anche sottoposte ad un costante trattamento di sanificazione con prodotto biocida, come da piano di controlli periodici messi in atto dall’azienda per tutelare la salute dei propri lavoratori e della comunità. L’efficacia di queste azioni è stata dimostrata anche dalle analisi con esito negativo effettuate nel luglio scorso.
Così come già fatto per la prevenzione del Covid, anche in questo caso per Ontex la salute e il benessere delle proprie persone sono la priorità numero uno. L’azienda non ha mai sottovalutato e mai sottovaluterà l’importanza della prevenzione e il rispetto delle persone dentro e fuori l’azienda”.